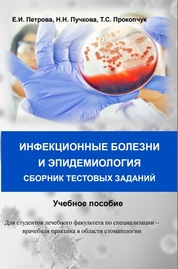

Энтеровирусные (неполио) инфекционные заболевания
В учебном пособии представлены современные сведения об этиологии, эпидемиологии, основных аспектах патогенеза, клинических проявлениях, диагностике, дифференциальной диагностике, лечении и профилактике энтеровирусных неполиомиелитных инфекций. Пособие предназначено для самостоятельной работы студент...
Сохранить в:
| Главный автор: | Петрова Е. И. |
|---|---|
| Другие авторы: | Минакова Ю. В., Портнягина Е. В., Лукашова Л. В., Рудиков А. А., Перфильева Д. Ю., Пучкова Н. Н. |
| Формат: | Книга |
| Язык: | Russian |
| Опубликовано: |
Томск
СибГМУ
2023
|
| Online-ссылка: | https://e.lanbook.com/book/389027 https://e.lanbook.com/img/cover/book/389027.jpg |
| Метки: |
Добавить метку
Нет меток, Требуется 1-ая метка записи!
|
Схожие документы
-
Детские инфекционные заболевания учебное пособие
Автор: Мурадова, Е. О. -
Инфекционные заболевания в спортивной среде учебное пособие
Автор: Ачкасов Е.Е -
Инфекционные заболевания, вызывающие чрезвычайные ситуации учебное пособие
Автор: Ильинских Е. Н.
Опубликовано: (2016) -
Инфекционные и паразитарные заболевания у детей Учебное пособие
Автор: Зелинская Д.И -
Воспалительные (инфекционные) заболевания нервной системы учебное пособие для студентов лечебного факультета
Автор: Долгов, А. М.